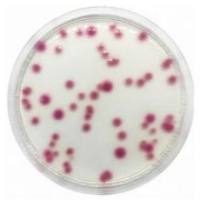
克雷伯菌显色培养基
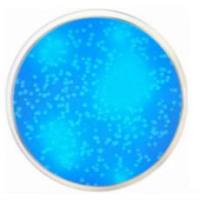
EC 琼脂(含荧光 MUG)
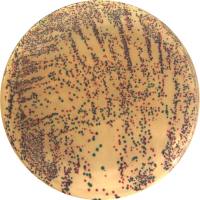
大肠杆菌肠杆菌显色琼脂(EEC)

万千商家帮你免费找货
0 人在求购买到急需产品
- 详细信息
- 技术资料
- 库存:
88
- 供应商:
子科生物
- 英文名:
Fuchsin ZIKERsic Sodium Sulfite Agar
- 规格:
250g
品红亚硫酸钠琼脂(远滕氏琼脂)
用途:用于饮用水、水源水中总大肠菌群的选择性分离和确证
深圳子科生物有限公司长期供应微生物检测产品,包括基础培养基、营养培养基、鉴别培养基、选择培养基、特殊培养基等,研发经验丰富,严格按照国家标准生产配制,质量稳定,发货快,全国免费送货上门,欢迎您来电咨询0755-66609091!
说明:
1、本产品的生产是参照最新的《中华人民共和国药典》2010年版配方配制、完全符合国家要求;
2、经过感观、无菌、质控菌检验、灵敏度检验、留样检验多重检验,符合国家质量标准,确保产品的质量稳定性;
3、如需了解产品的详细用途、配方、原理、用法、质量控制、产品图片等信息,请咨询在线客服或拨打客服热线!期待与您的合作!
品红亚硫酸钠琼脂(远滕氏琼脂)培养注意事项:
1、检查平板内是否干裂或染菌,如长菌请勿使用;
2、请在洁净的环境下操作,避免杂菌干扰;
3、经过预培养的培养基严禁使用;
4、在冰箱储存很久的培养基容易出现一些冷凝水,请在洁净的环境下将水倒出,然后在培养箱放置10-30Min,待其表面干燥后再接种;或在使用前,提前一到两周放置室温即可;
用途:用于饮用水、水源水中总大肠菌群的选择性分离和确证
深圳子科生物有限公司长期供应微生物检测产品,包括基础培养基、营养培养基、鉴别培养基、选择培养基、特殊培养基等,研发经验丰富,严格按照国家标准生产配制,质量稳定,发货快,全国免费送货上门,欢迎您来电咨询0755-66609091!
说明:
1、本产品的生产是参照最新的《中华人民共和国药典》2010年版配方配制、完全符合国家要求;
2、经过感观、无菌、质控菌检验、灵敏度检验、留样检验多重检验,符合国家质量标准,确保产品的质量稳定性;
3、如需了解产品的详细用途、配方、原理、用法、质量控制、产品图片等信息,请咨询在线客服或拨打客服热线!期待与您的合作!
品红亚硫酸钠琼脂(远滕氏琼脂)培养注意事项:
1、检查平板内是否干裂或染菌,如长菌请勿使用;
2、请在洁净的环境下操作,避免杂菌干扰;
3、经过预培养的培养基严禁使用;
4、在冰箱储存很久的培养基容易出现一些冷凝水,请在洁净的环境下将水倒出,然后在培养箱放置10-30Min,待其表面干燥后再接种;或在使用前,提前一到两周放置室温即可;
风险提示:丁香通仅作为第三方平台,为商家信息发布提供平台空间。用户咨询产品时请注意保护个人信息及财产安全,合理判断,谨慎选购商品,商家和用户对交易行为负责。对于医疗器械类产品,请先查证核实企业经营资质和医疗器械产品注册证情况。
技术资料暂无技术资料 索取技术资料
品红亚硫酸钠琼脂(远滕氏琼脂)
询价